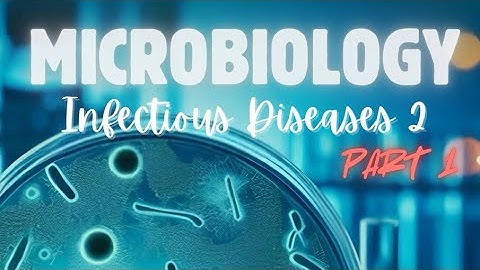

⬇ DOWNLOAD NOW
Kalau muncul iklan pop-up, tutup lalu klik tombol kembali
Download lagu Hepatitis C Part 2 secara gratis hanya untuk keperluan promosi. Dukung artis favorit kamu dengan membeli musik original di iTunes atau platform resmi lainnya.
 MOC 2021: Hepatitis C Virus - Part 2: HCV Treatment
MOC 2021: Hepatitis C Virus - Part 2: HCV Treatment
 Louie Me and Hepatitis C part 2 - 7 years later
Louie Me and Hepatitis C part 2 - 7 years later
 Part 2: How is hepatitis C treated?
Part 2: How is hepatitis C treated?
 Jake's Story - Hepatitis C - Part 2/3
Jake's Story - Hepatitis C - Part 2/3
 Psychiatric Complications of Hepatitis C Therapy: Part 2
Psychiatric Complications of Hepatitis C Therapy: Part 2
 Hepatitis C - An overview of the disease - UK HealthCare - Part 2
Hepatitis C - An overview of the disease - UK HealthCare - Part 2
 2 How is hepatitis C spread?
2 How is hepatitis C spread?
Hepatitis C ( Part 2 ) - Dr. Sara
Hepatitis C ( Part 2 ) - Dr. Sara